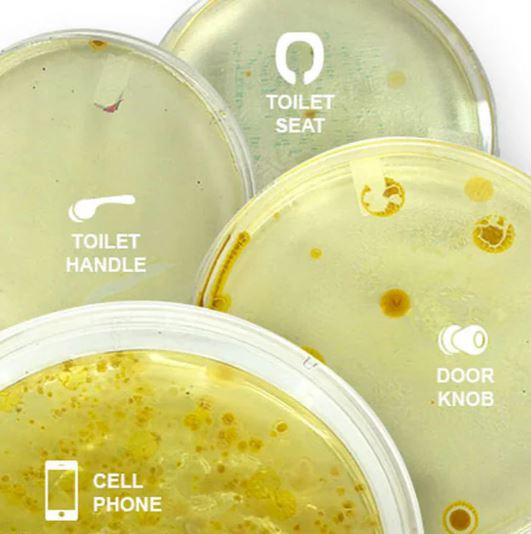

Note:
Because of the high demand, we regret to inform you that once our current stock runs out - we can't maintain this special discount offer.
We also must inform you that the product is unavailable for purchase on Amazon and eBay.
For more details on the remaining quantity, please scroll down.





How germy is your phone?
Your Phone harbors harmful bacteria and viruses. Sanify uses powerful UV-C lights to kill germs such as Salmonella, E. coli, MRSA, Staphylococcus, Coronavirus 229E that are growing on your every day items.

A Pocket Full of Germs? Not Anymore
Your phone goes everywhere, bathrooms, grocery stores, gym floors, collecting bacteria along the way. Every tap, swipe, and call transfers germs, turning your device into a germ haven.

SANITIZE ANYTHING
Sanify is perfect for sanitizing more than just your phone. From keys and earbuds to credit cards, jewelry, and even reusable face masks, this powerful UV sanitizer tackles germs on your everyday essentials with ease.

Customer satisfaction is our #1 priority
We make sure you are happy with your new product, you will love it, but in case you don't, you can simply return it within 90 days and we will give you a full refund its that simple.